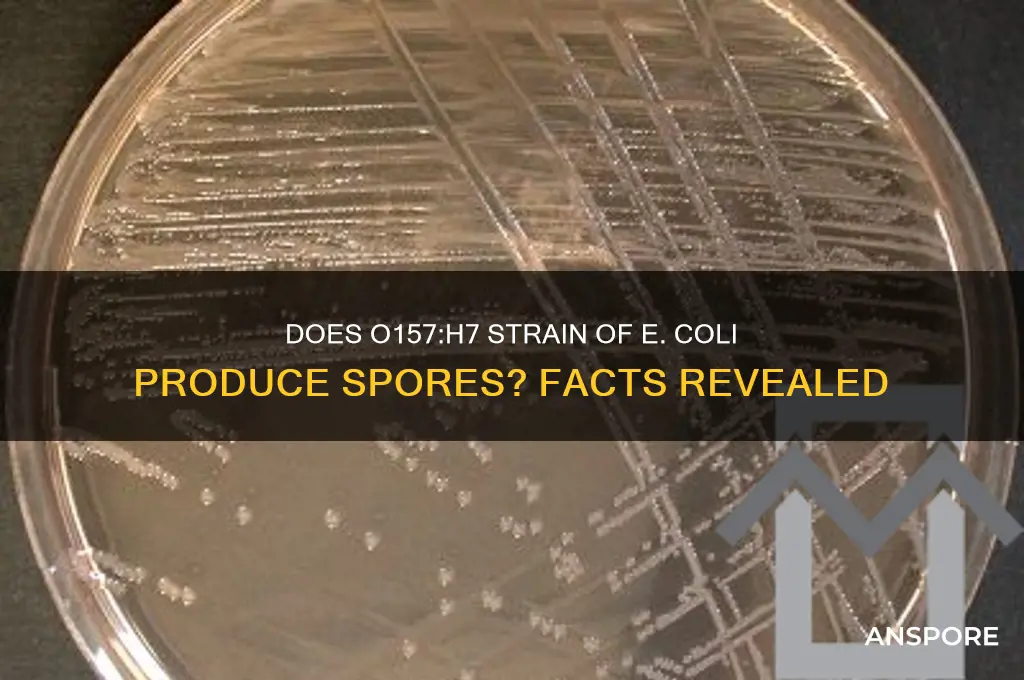
can o157h7 form spores

O157:H7, a pathogenic strain of *Escherichia coli*, is known for causing severe foodborne illnesses, including hemorrhagic colitis and hemolytic uremic syndrome. Despite its significant public health impact, this bacterium does not form spores under normal conditions. Unlike spore-forming bacteria such as *Clostridium botulinum* or *Bacillus anthracis*, O157:H7 lacks the genetic machinery required for sporulation. Spores are highly resistant structures that allow bacteria to survive harsh environmental conditions, but O157:H7 relies on other mechanisms, such as biofilm formation and stress response systems, to endure adverse environments. Understanding its inability to form spores is crucial for developing effective control and prevention strategies against this dangerous pathogen.
| Characteristics | Values |
|---|---|
| Can O157:H7 form spores? | No |
| Type of bacterium | Gram-negative, non-spore-forming |
| Scientific name | Escherichia coli O157:H7 |
| Pathogenicity | Shiga toxin-producing (STEC), causes hemorrhagic colitis and hemolytic uremic syndrome (HUS) |
| Transmission | Fecal-oral route, contaminated food/water, person-to-person contact |
| Survival outside host | Can survive for weeks in environment but does not form spores for long-term survival |
| Heat resistance | Killed by thorough cooking (71°C/160°F for 15 seconds) |
| Antimicrobial resistance | Some strains resistant to antibiotics like trimethoprim-sulfamethoxazole |
| Public health significance | Major foodborne pathogen, associated with outbreaks linked to undercooked meat, raw milk, and produce |
Explore related products
What You'll Learn

O157:H7 spore-forming capability
Escherichia coli O157:H7, a notorious pathogen responsible for severe foodborne illnesses, has long been studied for its survival mechanisms. One critical question in this context is whether O157:H7 can form spores, a resilient dormant structure that allows some bacteria to withstand harsh conditions. Unlike spore-forming bacteria such as *Clostridium botulinum* or *Bacillus cereus*, O157:H7 is not classified as a spore-former. This distinction is crucial because spore formation is a complex, energy-intensive process involving the synthesis of a protective endospore, which O157:H7 lacks the genetic machinery to produce.
From an analytical perspective, the absence of spore-forming capability in O157:H7 has significant implications for food safety and public health. While it cannot form spores, O157:H7 has evolved other survival strategies, such as biofilm formation and stress tolerance, which enable it to persist in environments like contaminated water, soil, and food processing surfaces. Understanding this limitation helps focus control measures on preventing contamination rather than combating spores. For instance, proper sanitation, temperature control, and hygiene practices are effective in reducing O157:H7 transmission, as spores are not a concern.
Instructively, laboratories and food safety professionals must differentiate between spore-forming and non-spore-forming pathogens when designing testing protocols. O157:H7 detection relies on methods like PCR, immunomagnetic separation, or culture-based techniques, which target its unique genetic and antigenic markers. Unlike spore-formers, which require heat or chemical treatments to eliminate spores, O157:H7 can be inactivated by standard pasteurization (71°C for 15 seconds) or thorough cooking (above 63°C). This knowledge is essential for developing targeted interventions in food processing and healthcare settings.
Persuasively, the inability of O157:H7 to form spores should not lead to complacency. While spores are not a concern, the pathogen’s low infectious dose (as few as 10–100 cells can cause illness) and ability to survive in diverse environments make it a formidable threat. Outbreaks linked to undercooked ground beef, contaminated produce, and unpasteurized dairy highlight the need for vigilance. Public health campaigns emphasizing safe food handling, such as separating raw and cooked foods, washing hands, and avoiding cross-contamination, remain critical in preventing O157:H7 infections.
Comparatively, the spore-forming capability of other pathogens, such as *Clostridium perfringens* or *Bacillus anthracis*, contrasts sharply with O157:H7. While spores allow these bacteria to survive extreme conditions like heat, desiccation, and chemicals, O157:H7’s survival is more dependent on immediate environmental factors. This difference underscores the importance of tailoring control strategies to the specific biology of each pathogen. For O157:H7, focusing on preventing initial contamination and rapid inactivation through cooking or sanitation is key, whereas spore-formers require more aggressive measures like autoclaving or sporostatic agents.
In conclusion, while O157:H7 cannot form spores, its survival strategies and low infectious dose demand targeted and rigorous control measures. By understanding its limitations and capabilities, stakeholders can implement effective interventions to mitigate the risk of O157:H7 contamination and protect public health. This knowledge bridges the gap between scientific understanding and practical application, ensuring safer food systems and communities.
How Music Impacts Sports Performance: Rhythm, Focus, and Motivation
You may want to see also

Conditions for spore formation in O157:H7
Escherichia coli O157:H7, a notorious foodborne pathogen, is primarily known for its ability to cause severe illness, including hemorrhagic colitis and hemolytic uremic syndrome. Unlike some bacterial species, such as *Clostridium botulinum* or *Bacillus cereus*, O157:H7 is not recognized as a spore-forming organism under typical conditions. However, understanding the conditions that might influence spore formation—or the lack thereof—is crucial for food safety and public health. Spore formation is a survival mechanism that allows certain bacteria to withstand extreme environmental conditions, such as heat, desiccation, and chemicals. For O157:H7, the absence of this ability is both a biological trait and a critical factor in its control and eradication.
From an analytical perspective, the genetic makeup of O157:H7 provides insight into its inability to form spores. Unlike spore-forming bacteria, which possess genes encoding sporulation proteins (e.g., *spo0A* and *sigK*), O157:H7 lacks these essential genetic components. Studies have shown that while O157:H7 can enter a viable but non-culturable (VBNC) state under stress, this is not equivalent to spore formation. The VBNC state is a survival strategy where cells remain alive but cannot be cultured on standard media, often triggered by nutrient deprivation, pH changes, or temperature shifts. For instance, exposure to temperatures below 4°C or pH levels below 4.5 can induce VBNC in O157:H7, but this does not confer the same resilience as spores.
Instructively, preventing O157:H7 contamination relies on understanding its limitations. Since it cannot form spores, control measures focus on eliminating vegetative cells. Practical tips include maintaining proper refrigeration (below 4°C) to slow bacterial growth, ensuring thorough cooking (internal temperature of 75°C or 167°F) to kill cells, and avoiding cross-contamination during food preparation. For example, sanitizing surfaces with a 10% bleach solution (1 part bleach to 9 parts water) can effectively reduce O157:H7 populations. Additionally, water treatment facilities should employ filtration and chlorination to remove and inactivate the bacterium, as it is often transmitted via contaminated water.
Comparatively, the inability of O157:H7 to form spores contrasts sharply with spore-forming pathogens like *Clostridium perfringens*, which can survive boiling temperatures. This distinction highlights the importance of tailoring control strategies to the specific biology of the pathogen. While spores require extreme measures, such as autoclaving at 121°C for 15 minutes, O157:H7 is more susceptible to conventional sanitation practices. However, its persistence in low-moisture environments, such as dry foods or soil, underscores the need for vigilance even in non-spore-forming organisms.
Descriptively, the environmental conditions that might theoretically induce spore-like states in O157:H7 remain speculative. Laboratory experiments have explored the effects of osmotic stress, UV radiation, and nutrient depletion, but no evidence supports true spore formation. For instance, exposure to 20% NaCl for 24 hours reduces O157:H7 viability by 99.9%, but surviving cells do not exhibit spore characteristics. Similarly, UV treatment at doses of 1000 J/m² inactivates most cells but does not trigger sporulation. These findings reinforce the consensus that O157:H7 lacks the biological machinery for spore formation, making its control a matter of targeting vegetative cells rather than resilient spores.
In conclusion, while O157:H7 cannot form spores, its survival strategies under stress conditions demand targeted control measures. By focusing on its genetic limitations and environmental vulnerabilities, food safety protocols can effectively mitigate the risk of contamination. This knowledge not only informs practical interventions but also underscores the importance of understanding pathogen biology in public health efforts.
Create Stunning Fern Spore Prints: A Simple DIY Guide
You may want to see also

Differences between O157:H7 and spore-forming bacteria
Escherichia coli O157:H7 is a pathogenic strain of bacteria notorious for causing severe foodborne illnesses, yet it lacks the ability to form spores, a survival mechanism employed by other bacteria like Clostridium botulinum and Bacillus cereus. This distinction is critical because spore formation allows certain bacteria to withstand extreme conditions such as heat, desiccation, and chemicals, making them harder to eradicate. O157:H7, in contrast, remains vegetative and is more susceptible to standard sanitation methods like pasteurization and thorough cooking. Understanding this difference is essential for food safety protocols, as it highlights the importance of targeted interventions to control these pathogens effectively.
From a practical standpoint, the inability of O157:H7 to form spores means it is more vulnerable to environmental stressors. For instance, heating food to 160°F (71°C) for at least 15 seconds can reliably kill O157:H7 cells, whereas spore-forming bacteria require much higher temperatures (e.g., 250°F or 121°C) and longer durations to eliminate their spores. This makes O157:H7 easier to manage in food processing, provided proper cooking and handling practices are followed. However, its vegetative state also means it can multiply rapidly in favorable conditions, such as undercooked ground beef or contaminated produce, emphasizing the need for strict hygiene and temperature control.
The lifecycle of O157:H7 contrasts sharply with that of spore-forming bacteria. While O157:H7 relies on active replication in a host or nutrient-rich environment, spore-forming bacteria can enter a dormant spore state when conditions are unfavorable, only to revive when conditions improve. This dormancy allows spores to persist in soil, water, and food processing equipment for years, posing a long-term contamination risk. O157:H7, however, cannot survive outside a host or food source for extended periods, making it less likely to establish persistent environmental reservoirs. This difference underscores the need for distinct control strategies: regular cleaning and sanitation for O157:H7, versus more aggressive measures like autoclaving for spore-forming bacteria.
Finally, the inability of O157:H7 to form spores has implications for public health responses to outbreaks. Since O157:H7 is more easily destroyed by heat and disinfectants, outbreaks can often be contained through targeted recalls, cooking advisories, and improved sanitation practices. Spore-forming bacteria, however, require more drastic measures, such as high-pressure processing or irradiation, to ensure food safety. For example, a spinach farm contaminated with O157:H7 might resolve the issue through thorough washing and proper storage, whereas Bacillus cereus spores would necessitate more intensive decontamination methods. Recognizing these differences empowers food producers and regulators to tailor their interventions for maximum effectiveness.
Can Mold Spores Infiltrate Your Mattress? Prevention and Detection Tips
You may want to see also

Role of stress in O157:H7 survival
Stress plays a pivotal role in the survival of *Escherichia coli* O157:H7, a pathogen notorious for its ability to persist in harsh environments. Unlike spore-forming bacteria such as *Clostridium botulinum*, O157:H7 cannot form spores, yet it exhibits remarkable resilience under stressful conditions. This survival mechanism is critical for its transmission and persistence in food, water, and animal reservoirs. Stress responses in O157:H7 are triggered by factors like temperature fluctuations, pH changes, and nutrient deprivation, which activate specific genetic pathways that enhance its durability. Understanding these stress-induced adaptations is essential for developing effective control strategies in food safety and public health.
One of the key stress responses in O157:H7 is the activation of the RpoS regulon, a set of genes that promote survival during starvation and oxidative stress. For instance, exposure to low temperatures (e.g., 4°C, typical of refrigeration) induces the expression of cold-shock proteins, which stabilize the bacterial cell membrane and maintain metabolic activity. Similarly, acidic environments, such as those found in the stomach (pH 2–3), trigger the production of acid resistance proteins, allowing the bacterium to survive passage through the gastrointestinal tract. These adaptive mechanisms highlight how O157:H7 leverages stress to ensure its longevity, even in the absence of spore formation.
Practical implications of this stress-induced survival are evident in food processing and handling. For example, while pasteurization (72°C for 15 seconds) effectively kills O157:H7, sublethal heat treatments (e.g., 55°C for 10 minutes) can paradoxically enhance its stress tolerance. This phenomenon, known as cross-protection, occurs when exposure to one stressor primes the bacterium to withstand others. To mitigate this risk, food processors should ensure thermal treatments reach lethal thresholds and avoid partial processing. Additionally, maintaining proper refrigeration temperatures (below 4°C) slows but does not eliminate O157:H7 growth, emphasizing the need for rigorous hygiene practices.
Comparatively, the inability of O157:H7 to form spores contrasts with spore-forming pathogens like *Bacillus cereus*, which can survive extreme conditions for years. However, O157:H7’s stress-induced survival mechanisms compensate for this limitation, enabling it to persist in diverse environments. For instance, in cattle intestines, the bacterium encounters bile salts, which act as stressors but also serve as signals for virulence gene expression. This dual role of stress underscores its significance in both survival and pathogenesis. By targeting these stress responses, researchers are exploring novel interventions, such as antimicrobial peptides or phage therapy, to disrupt O157:H7’s resilience.
In conclusion, while O157:H7 cannot form spores, its stress-induced survival strategies make it a formidable pathogen. From cold-shock proteins to acid resistance mechanisms, these adaptations ensure its persistence in challenging environments. For food safety professionals, understanding these responses is crucial for designing effective control measures. By addressing stressors like temperature, pH, and nutrient availability, we can minimize the risk of O157:H7 contamination and protect public health. This knowledge also informs the development of targeted interventions, paving the way for more resilient food systems.
Are Moss Spores Poisonous? Uncovering the Truth About Moss Safety
You may want to see also

Implications of O157:H7 spore formation for food safety
Escherichia coli O157:H7 is a notorious foodborne pathogen, but its inability to form spores has been a critical factor in managing its spread. Unlike spore-forming bacteria such as Clostridium botulinum, O157:H7 relies on vegetative cells for survival, which are more susceptible to heat, desiccation, and sanitizers. This vulnerability has guided food safety protocols, focusing on preventing contamination rather than eradicating resilient spores. However, recent studies have explored whether environmental stressors might induce spore-like survival mechanisms in O157:H7, raising concerns about its potential adaptability.
If O157:H7 were to develop spore-forming capabilities, the implications for food safety would be profound. Spores can survive extreme conditions—temperatures above 100°C, pH levels below 3, and prolonged dehydration—making them nearly impossible to eliminate in food processing. For instance, canned foods rely on sterilization at 121°C for 15 minutes to destroy spores, a process that would be unnecessary for non-spore-forming pathogens. A spore-forming O157:H7 could bypass such safeguards, increasing the risk of contamination in processed meats, dairy, and produce. This would necessitate a complete overhaul of food safety standards, including more aggressive heat treatments and novel preservation methods.
The economic and logistical challenges of adapting to spore-forming O157:H7 cannot be overstated. Current Good Manufacturing Practices (GMPs) and Hazard Analysis and Critical Control Points (HACCP) systems are designed around the pathogen’s non-spore-forming nature. If spores were introduced, industries would face higher costs for extended thermal processing, chemical treatments, and monitoring. Small-scale producers, in particular, might struggle to comply with new regulations, potentially leading to market consolidation. Additionally, consumer trust in food safety could erode, impacting global trade and public health.
Preventing such a scenario requires proactive research and surveillance. Scientists must investigate whether genetic mutations or horizontal gene transfer could enable O157:H7 to form spores, especially in stressed environments like water treatment plants or soil. Food safety agencies should collaborate to develop contingency plans, including rapid detection methods for spore-like structures and targeted antimicrobial interventions. For example, phage therapy or bacteriostatic agents could be explored to inhibit spore development. Public education campaigns could also emphasize the importance of proper cooking (e.g., reaching 75°C for 15 seconds) and hygiene to reduce exposure risks.
In conclusion, while O157:H7 currently lacks spore-forming ability, the hypothetical emergence of this trait would revolutionize food safety paradigms. The industry must remain vigilant, investing in research and preparedness to mitigate risks before they materialize. By understanding the potential consequences and taking preemptive action, stakeholders can safeguard global food systems against this evolving threat.
Can Botulism Spores Survive in Water? Uncovering the Truth
You may want to see also
Frequently asked questions
No, O157:H7, a strain of *Escherichia coli* (E. coli), does not form spores. It is a non-spore-forming bacterium.
Knowing that O157:H7 does not form spores is important because spore-forming bacteria can survive harsh conditions, such as heat and desiccation, making them harder to eliminate. Since O157:H7 does not form spores, it is more susceptible to standard disinfection methods.
No, *Escherichia coli* as a species, including O157:H7, is not known to form spores. Spore formation is a characteristic of other bacterial genera, such as *Bacillus* and *Clostridium*.











